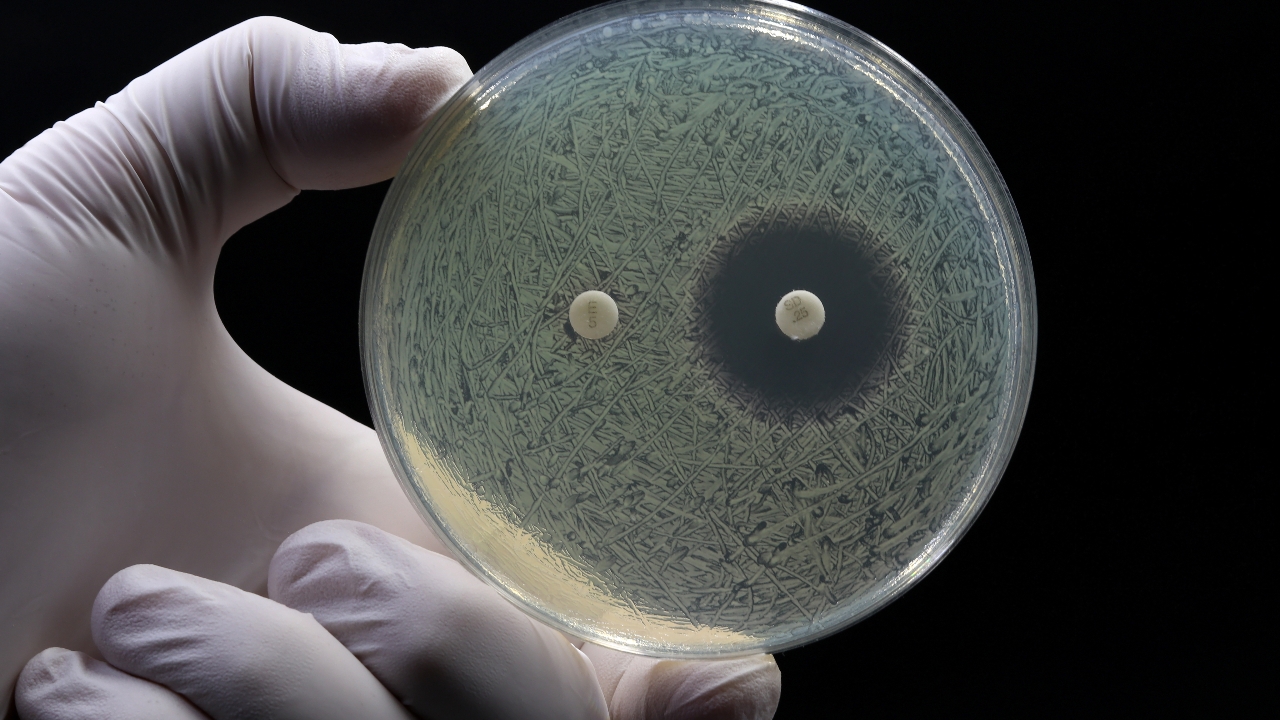
AI ช่วยคิดค้นยาปฏิชีวนะตัวใหม่ ฆ่าเชื้อหนองใน และ เชื้อแบคทีเรียดื้อยา

ทีมนักวิจัย ร่วมกับ AI คิดค้นยาปฏิชีวนะ 2 สูตรใหม่ ฆ่าเชื้อหนองในและเชื้อแบคทีเรียดื้อยาะ MRSA หลังมนุษย์เผชิญวิกฤตเชื้อดื้อยาคร่าชีวิตนับล้านต่อปี
วันที่ 14 สิงหาคม 2568 ทีมนักวิทยาศาสตร์จากสถาบันเทคโนโลยีแมสซาชูเซตส์ (MIT) ของสหรัฐฯ ประสบความสำเร็จในการใช้เทคโนโลยีปัญญาประดิษฐ์ (AI) ออกแบบยาปฏิชีวนะชนิดใหม่ 2 ชนิด ที่สามารถกำจัดเชื้อโรคสุดอันตราย ได้แก่ เชื้อกอนอร์เรีย หรือ หนองใน (Neisseria gonorrhoeae) ที่มักจะดื้อยาหลายขนาน และเชื้อแบคทีเรียดื้อยา Methicillin-resistant Staphylococcus aureus (MRSA) ได้อย่างมีประสิทธิภาพ
นักวิทยาศาสตร์เปิดเผยว่า ผลการทดสอบในห้องปฏิบัติการและกับสัตว์ทดลองพบว่า ยาปฏิชีวนะทั้งสองชนิดสามารถฆ่าเชื้อได้จริง โดยไม่ทำลายเซลล์ร่างกายของสิ่งมีชีวิต อย่างไรก็ตาม นักวิจัยเตือนว่ากว่าจะนำมาใช้รักษาผู้ป่วยจริงยังต้องใช้เวลาหลายปี ในการพัฒนาและผ่านการทดลองทางคลินิกอย่างเข้มงวด
ผู้เชี่ยวชาญระบุว่า ความสำเร็จครั้งนี้อาจเป็นก้าวสำคัญในการก้าวสู่ "ยุครุ่งเรืองครั้งที่สอง" ของการค้นพบยาปฏิชีวนะ หลังทั่วโลกเผชิญวิกฤตเชื้อดื้อยา ซึ่งองค์การอนามัยโลก ชี้ว่าคร่าชีวิตผู้คนมากกว่า 1 ล้านคนต่อปี.
ที่มา BBC